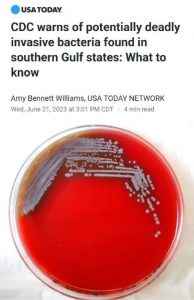

Your Daily Dose of Germ Theory Fear Porn – Brought to you by the CDC & MSM
June 23, 2023

Are you ready for another bacteria to stress over?
If so, the CDC is promoting (HERE) its latest “potentially deadly” Germ – but in reality is entirely harmless.
In fact, most people identified with it “shake it off” without any problems whatsoever.
The CDC & MSM wants you to worry about the scary headlines that they used to sucker you & instill fear in you.

IT’S IMPORTANT TO READ BEYOND THE HEADLINES !!!
To avoid being suckered please look over these Warning Signs You’ve Been Tricked By Virologists, HERE
Michael McKay retired from the financial industry in 2014. He then went back to school and is now advises the implementation of health improvement and self-care strategies. He’s also the author of Secrets About Money That Put You At Risk. He can be reached at [email protected]

